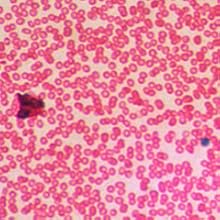

Some deliveries may take a little longer than usual due to regional shipping conditions.
Customer Services
Copyright © 2025 Desertcart Holdings Limited




Levenhuk G50 High Transparency Microscope Blank Slides with Polished Edges for Preparing Laboratory Specimens

Trustpilot
2 days ago
1 month ago
1 week ago
3 weeks ago